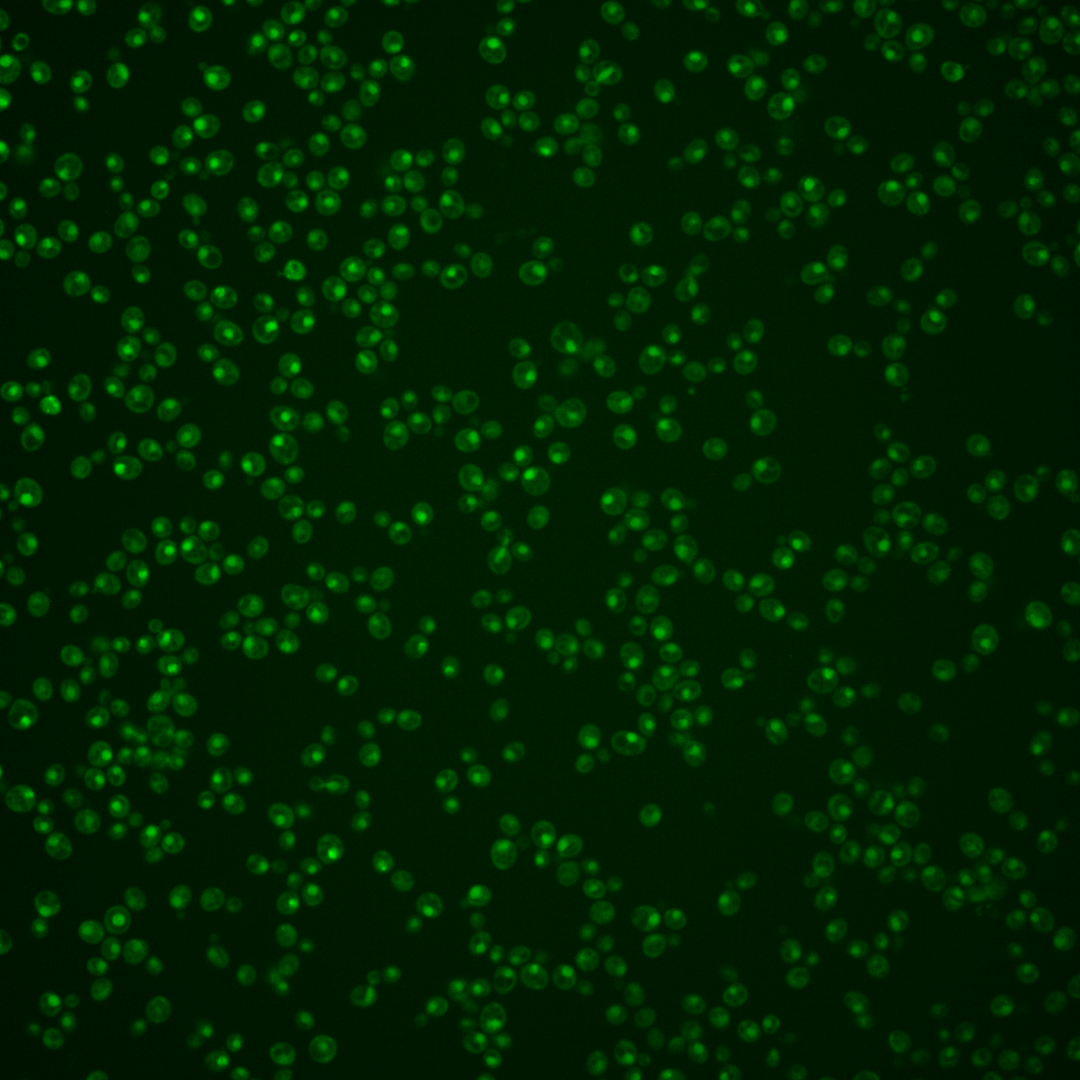

| Standard name | |
|---|---|
| Human Ortholog | |
| Description | Subunit of DNA polymerase delta (polymerase III); essential for cell viability; involved in DNA replication and DNA repair; forms a complex with Rev3p, Rev7p and Pol32p; relocalizes to the cytosol in response to hypoxia |
Micrographs




















































































Sub-cellular Localization
Yeast GFP Assignment
Protein Abundance
Localization Change
External localization resources
| ensLOC | DeepLoc | |||||||||||||||||||||||
|---|---|---|---|---|---|---|---|---|---|---|---|---|---|---|---|---|---|---|---|---|---|---|---|---|
| Localization | WT1 | WT2 | WT3 | RAP60 | RAP140 | RAP220 | RAP300 | RAP380 | RAP460 | RAP540 | RAP620 | RAP700 | HU80 | HU120 | HU160 | rpd3Δ_1 | rpd3Δ_2 | rpd3Δ_3 | WT1 | WT2 | WT3 | AF100 | AF140 | AF180 |
| Cortical Patches | 0 | 0 | 0 | 0 | 0 | 0 | 0 | 0 | – | 0 | 0 | 0 | 0 | 0 | 0 | 0 | 0 | 0 | 1 | 0 | 1 | 0 | 1 | 0 |
| Bud | 0 | 0 | 1 | 0 | 1 | 4 | 6 | 17 | – | 7 | 6 | 4 | 0 | 0 | 0 | 0 | 0 | 0 | 3 | 1 | 1 | 2 | 2 | 3 |
| Bud Neck | 0 | 0 | 0 | 0 | 0 | 0 | 0 | 0 | – | 0 | 0 | 0 | 2 | 0 | 1 | 0 | 0 | 0 | 0 | 0 | 0 | 0 | 0 | 0 |
| Bud Site | 0 | 0 | 1 | 1 | 0 | 13 | 22 | 15 | – | 22 | 20 | 27 | 0 | 0 | 0 | 1 | 0 | 0 | – | – | – | – | – | – |
| Cell Periphery | 0 | 0 | 0 | 0 | 0 | 0 | 0 | 0 | – | 0 | 0 | 0 | 0 | 0 | 1 | 0 | 0 | 0 | 0 | 0 | 0 | 0 | 0 | 0 |
| Cytoplasm | 11 | 9 | 15 | 16 | 21 | 27 | 35 | 36 | – | 35 | 23 | 25 | 32 | 43 | 52 | 21 | 10 | 14 | 1 | 2 | 1 | 1 | 3 | 2 |
| Endoplasmic Reticulum | 1 | 0 | 0 | 1 | 0 | 0 | 0 | 0 | – | 0 | 0 | 0 | 0 | 2 | 2 | 8 | 10 | 8 | 0 | 0 | 1 | 0 | 3 | 2 |
| Endosome | 0 | 0 | 1 | 0 | 0 | 0 | 0 | 0 | – | 0 | 0 | 0 | 0 | 3 | 2 | 0 | 0 | 2 | 3 | 2 | 5 | 0 | 1 | 6 |
| Golgi | 0 | 0 | 0 | 0 | 0 | 0 | 0 | 0 | – | 0 | 0 | 0 | 2 | 1 | 0 | 2 | 0 | 0 | 3 | 0 | 2 | 0 | 0 | 1 |
| Mitochondria | 10 | 10 | 134 | 73 | 140 | 298 | 439 | 377 | – | 401 | 413 | 445 | 2 | 4 | 0 | 23 | 27 | 10 | 4 | 1 | 2 | 0 | 2 | 6 |
| Nucleus | 230 | 210 | 381 | 278 | 274 | 410 | 467 | 486 | – | 434 | 417 | 430 | 230 | 280 | 261 | 417 | 385 | 351 | 225 | 204 | 380 | 116 | 123 | 134 |
| Nuclear Periphery | 0 | 1 | 0 | 1 | 3 | 1 | 14 | 6 | – | 5 | 3 | 6 | 0 | 0 | 0 | 7 | 4 | 5 | 0 | 0 | 2 | 0 | 0 | 0 |
| Nucleolus | 1 | 3 | 5 | 3 | 8 | 17 | 27 | 58 | – | 27 | 26 | 26 | 1 | 0 | 0 | 6 | 4 | 2 | 4 | 5 | 11 | 1 | 2 | 4 |
| Peroxisomes | 1 | 0 | 0 | 0 | 0 | 0 | 0 | 0 | – | 0 | 0 | 0 | 0 | 1 | 0 | 0 | 0 | 0 | 0 | 0 | 0 | 0 | 0 | 0 |
| SpindlePole | 1 | 0 | 1 | 2 | 0 | 4 | 3 | 5 | – | 3 | 3 | 0 | 1 | 4 | 3 | 4 | 1 | 2 | 2 | 1 | 6 | 0 | 1 | 3 |
| Vac/Vac Membrane | 9 | 11 | 2 | 1 | 7 | 8 | 12 | 8 | – | 9 | 14 | 10 | 2 | 2 | 4 | 22 | 16 | 14 | 9 | 10 | 29 | 19 | 42 | 44 |
| Unique Cell Count | 250 | 227 | 438 | 306 | 343 | 536 | 683 | 686 | 631 | 582 | 607 | 264 | 331 | 321 | 462 | 413 | 382 | 263 | 236 | 453 | 145 | 190 | 215 | |
| Labelled Cell Count | 264 | 244 | 541 | 376 | 454 | 782 | 1025 | 1008 | 943 | 925 | 973 | 272 | 340 | 326 | 511 | 457 | 408 | 263 | 236 | 453 | 145 | 190 | 215 | |
Yeast GFP Assignment
Protein Abundance
| Screen | WT1 | WT2 | WT3 | RAP60 | RAP140 | RAP220 | RAP300 | RAP380 | RAP460 | RAP540 | RAP620 | RAP700 | HU80 | HU120 | HU160 | rpd3Δ_1 | rpd3Δ_2 | rpd3Δ_3 | AF100 | AF140 | AF180 |
|---|---|---|---|---|---|---|---|---|---|---|---|---|---|---|---|---|---|---|---|---|---|
| Mean Cell GFP Intensity (1e-4) | 5.9 | 5.8 | 4.1 | 4.3 | 4.0 | 3.9 | 3.6 | 3.6 | – | 3.3 | 3.3 | 3.3 | 6.1 | 6.2 | 6.2 | 7.0 | 7.0 | 7.4 | 6.5 | 7.0 | 6.8 |
| Std Deviation (1e-4) | 0.9 | 0.8 | 0.8 | 1.3 | 1.2 | 1.2 | 1.6 | 1.4 | – | 0.9 | 1.0 | 0.8 | 1.3 | 1.3 | 1.4 | 1.4 | 1.3 | 1.5 | 1.4 | 1.7 | 1.6 |
| Intensity Change (Log2) | – | – | – | 0.04 | -0.06 | -0.1 | -0.22 | -0.21 | – | -0.33 | -0.33 | -0.34 | 0.57 | 0.57 | 0.57 | 0.77 | 0.75 | 0.83 | 0.66 | 0.75 | 0.72 |
Localization Change
| Localization | RAP60 | RAP140 | RAP220 | RAP300 | RAP380 | RAP460 | RAP540 | RAP620 | RAP700 | HU80 | HU120 | HU160 | rpd3Δ_1 | rpd3Δ_2 | rpd3Δ_3 |
|---|---|---|---|---|---|---|---|---|---|---|---|---|---|---|---|
| Cortical Patches | 0 | 0 | 0 | 0 | 0 | – | 0 | 0 | 0 | 0 | 0 | 0 | 0 | 0 | 0 |
| Bud | 0 | 0 | 0 | 0 | 0 | – | 0 | 0 | 0 | 0 | 0 | 0 | 0 | 0 | 0 |
| Bud Neck | 0 | 0 | 0 | 0 | 0 | – | 0 | 0 | 0 | 0 | 0 | 0 | 0 | 0 | 0 |
| Bud Site | 0 | 0 | 0 | 0 | 0 | – | 0 | 0 | 0 | 0 | 0 | 0 | 0 | 0 | 0 |
| Cell Periphery | 0 | 0 | 0 | 0 | 0 | – | 0 | 0 | 0 | 0 | 0 | 0 | 0 | 0 | 0 |
| Cytoplasm | 1.2 | 1.8 | 1.2 | 1.3 | 1.4 | – | 1.6 | 0.4 | 0.6 | 4.5 | 5.0 | 6.1 | 0.9 | -0.9 | 0.2 |
| Endoplasmic Reticulum | 0 | 0 | 0 | 0 | 0 | – | 0 | 0 | 0 | 0 | 0 | 0 | 0 | 0 | 0 |
| Endosome | 0 | 0 | 0 | 0 | 0 | – | 0 | 0 | 0 | 0 | 0 | 0 | 0 | 0 | 0 |
| Golgi | 0 | 0 | 0 | 0 | 0 | – | 0 | 0 | 0 | 0 | 0 | 0 | 0 | 0 | 0 |
| Mitochondria | 0 | 0 | 0 | 0 | 0 | – | 0 | 0 | 0 | -9.7 | -10.5 | -10.9 | -10.1 | -9.0 | -10.5 |
| Nucleus | 1.6 | -2.7 | -4.2 | -7.1 | -6.3 | – | -6.9 | -5.9 | -6.2 | 0.1 | -0.9 | -2.1 | 1.5 | 3.0 | 2.3 |
| Nuclear Periphery | 0 | 0 | 0 | 0 | 0 | – | 0 | 0 | 0 | 0 | 0 | 0 | 0 | 0 | 0 |
| Nucleolus | 0 | 0 | 0 | 0 | 0 | – | 0 | 0 | 0 | 0 | 0 | 0 | 0.2 | 0 | 0 |
| Peroxisomes | 0 | 0 | 0 | 0 | 0 | – | 0 | 0 | 0 | 0 | 0 | 0 | 0 | 0 | 0 |
| SpindlePole | 0 | 0 | 0 | 0 | 0 | – | 0 | 0 | 0 | 0 | 0 | 0 | 0 | 0 | 0 |
| Vacuole | 0 | 0 | 0 | 1.9 | 0 | – | 0 | 2.5 | 1.8 | 0 | 0 | 0 | 4.0 | 3.5 | 3.3 |
External localization resources
Images






























Protein Concentration and Protein Localization Data
| R1 | R2 | R3 | ||||||||||||||||
|---|---|---|---|---|---|---|---|---|---|---|---|---|---|---|---|---|---|---|
| G1 Pre-START | G1 Post-START | S/G2 | Metaphase | Anaphase | Telophase | G1 Pre-START | G1 Post-START | S/G2 | Metaphase | Anaphase | Telophase | G1 Pre-START | G1 Post-START | S/G2 | Metaphase | Anaphase | Telophase | |
| Concentration | 1.8306 | 1.9086 | 1.9131 | 1.8536 | 1.3312 | 1.53 | 3.536 | 3.8242 | 3.8103 | 3.4239 | 2.9366 | 3.2777 | 0.0652 | 0.4978 | 0.2059 | 0.3483 | 0.8321 | 0.1577 |
| Actin | 0.0124 | 0 | 0.0044 | 0 | 0.001 | 0.0001 | 0.0286 | 0.0001 | 0.0089 | 0.0086 | 0.0027 | 0.0001 | 0.0082 | 0 | 0.0074 | 0 | 0.0017 | 0.0003 |
| Bud | 0.0002 | 0 | 0.0001 | 0 | 0.0002 | 0.0001 | 0.0013 | 0.0001 | 0.0003 | 0.001 | 0.0017 | 0.0002 | 0.0005 | 0 | 0.0001 | 0 | 0.0003 | 0.0005 |
| Bud Neck | 0.0039 | 0 | 0.0004 | 0 | 0.0004 | 0.0003 | 0.0081 | 0.0004 | 0.0058 | 0.0007 | 0.0011 | 0.0007 | 0.0007 | 0.0001 | 0.0001 | 0 | 0.0003 | 0.0017 |
| Bud Periphery | 0.0005 | 0 | 0.0002 | 0 | 0.0007 | 0.0002 | 0.0037 | 0 | 0.0007 | 0.0009 | 0.0048 | 0.0011 | 0.0004 | 0 | 0.0001 | 0 | 0.0001 | 0.0005 |
| Bud Site | 0.001 | 0 | 0.0029 | 0 | 0.0003 | 0.0001 | 0.005 | 0.0036 | 0.0026 | 0.0069 | 0.0013 | 0.0001 | 0.0249 | 0.0001 | 0.0003 | 0 | 0.0011 | 0.0018 |
| Cell Periphery | 0.0001 | 0 | 0.0001 | 0 | 0.0001 | 0 | 0.0016 | 0 | 0.0003 | 0.0002 | 0.0006 | 0.0001 | 0.0005 | 0 | 0 | 0 | 0 | 0.0001 |
| Cytoplasm | 0.0018 | 0.0001 | 0.0002 | 0.0002 | 0.0008 | 0.0001 | 0.0058 | 0.0004 | 0.0112 | 0.005 | 0.0027 | 0.0001 | 0.0468 | 0.0004 | 0.0067 | 0.0001 | 0.1256 | 0.0041 |
| Cytoplasmic Foci | 0.003 | 0 | 0.0002 | 0 | 0.0021 | 0 | 0.004 | 0.0064 | 0.0023 | 0.0076 | 0.0005 | 0 | 0.0128 | 0 | 0.0187 | 0 | 0.0579 | 0.0192 |
| Eisosomes | 0.0001 | 0 | 0.0001 | 0 | 0.0001 | 0 | 0.0005 | 0 | 0.0002 | 0.0002 | 0.0001 | 0 | 0.0001 | 0 | 0 | 0 | 0 | 0 |
| Endoplasmic Reticulum | 0.002 | 0 | 0.0002 | 0 | 0.0013 | 0 | 0.0081 | 0.0004 | 0.0018 | 0.0009 | 0.0068 | 0.0001 | 0.0047 | 0 | 0.0124 | 0 | 0.0129 | 0.0006 |
| Endosome | 0.0073 | 0 | 0.0011 | 0 | 0.0148 | 0.0001 | 0.0163 | 0.0015 | 0.0078 | 0.0089 | 0.0112 | 0.0001 | 0.0142 | 0 | 0.0145 | 0 | 0.1799 | 0.033 |
| Golgi | 0.0022 | 0 | 0.0007 | 0 | 0.004 | 0 | 0.006 | 0.0004 | 0.0024 | 0.0059 | 0.0014 | 0 | 0.0017 | 0 | 0.0028 | 0 | 0.0266 | 0.0043 |
| Lipid Particles | 0.0032 | 0 | 0.0029 | 0 | 0.0029 | 0.0001 | 0.0052 | 0.0005 | 0.0046 | 0.0009 | 0.006 | 0.0001 | 0.0016 | 0 | 0.0033 | 0 | 0.0053 | 0.0025 |
| Mitochondria | 0.004 | 0 | 0.0021 | 0.0001 | 0.0274 | 0.002 | 0.0148 | 0.0002 | 0.0096 | 0.0026 | 0.0201 | 0.0011 | 0.0014 | 0.0002 | 0.0011 | 0.0001 | 0.009 | 0.0009 |
| None | 0.0102 | 0 | 0.0001 | 0.0004 | 0.0007 | 0 | 0.0067 | 0.0004 | 0.0052 | 0.0429 | 0.0006 | 0.0001 | 0.0248 | 0 | 0.0011 | 0 | 0.0017 | 0.0002 |
| Nuclear Periphery | 0.0088 | 0.001 | 0.0016 | 0.0012 | 0.01 | 0.0025 | 0.0215 | 0.0087 | 0.0278 | 0.0008 | 0.0301 | 0.0011 | 0.0178 | 0.0022 | 0.0094 | 0.0011 | 0.0229 | 0.0014 |
| Nucleolus | 0.0147 | 0.0108 | 0.0105 | 0.0103 | 0.0221 | 0.0177 | 0.0182 | 0.0199 | 0.0053 | 0.0031 | 0.022 | 0.019 | 0.0061 | 0.0122 | 0.0104 | 0.0047 | 0.0041 | 0.0119 |
| Nucleus | 0.9041 | 0.9866 | 0.9704 | 0.9661 | 0.8939 | 0.9747 | 0.8176 | 0.9533 | 0.8938 | 0.8943 | 0.854 | 0.9734 | 0.8007 | 0.9839 | 0.905 | 0.9937 | 0.5299 | 0.908 |
| Peroxisomes | 0.0067 | 0 | 0.0003 | 0 | 0.0003 | 0 | 0.0018 | 0.0014 | 0.0021 | 0.0012 | 0.0005 | 0.0001 | 0.0009 | 0 | 0.0019 | 0 | 0.0084 | 0.0007 |
| Punctate Nuclear | 0.0118 | 0.0013 | 0.0008 | 0.0216 | 0.0134 | 0.0012 | 0.0121 | 0.0017 | 0.0049 | 0.0059 | 0.018 | 0.0015 | 0.0287 | 0.0005 | 0.0041 | 0.0001 | 0.0053 | 0.0031 |
| Vacuole | 0.0013 | 0 | 0.0002 | 0 | 0.0017 | 0.0002 | 0.01 | 0.0005 | 0.0014 | 0.0012 | 0.0063 | 0.0006 | 0.0016 | 0.0002 | 0.0003 | 0 | 0.0041 | 0.0047 |
| Vacuole Periphery | 0.0008 | 0 | 0.0002 | 0 | 0.0017 | 0.0004 | 0.003 | 0.0002 | 0.001 | 0.0004 | 0.0075 | 0.0002 | 0.0007 | 0.0001 | 0.0004 | 0 | 0.0027 | 0.0006 |
Sequencing Data
| R1 | R2 | |||||||||
|---|---|---|---|---|---|---|---|---|---|---|
| G1 Post-START | S/G2 | Metaphase | Anaphase | Telophase | G1 Post-START | S/G2 | Metaphase | Anaphase | Telophase | |
| Gene Expression | 21.1034 | 8.0851 | 12.9988 | 18.5194 | 18.0781 | 16.572 | 13.795 | 15.6327 | 18.7203 | 29.5316 |
| Translational Efficiency | 1.2102 | 1.5899 | 0.7634 | 0.8593 | 1.0322 | 1.7137 | 1.1015 | 0.6285 | 0.7318 | 0.6819 |
Hit Data
| Dataset | Hit |
|---|---|
| Protein Concentration | ✘ |
| Protein Localization | ✘ |
| Gene Expression | ✔ |
| Translational Efficiency | ✘ |
Endocytosis
| Temp | Actin Patch (Sac6-tdTomato) | Cortical Patch (Sla1-GFP) | Late Endosome (Snf7-GFP) | Vacuole (Vph1-GFP) |
|---|---|---|---|---|
| 37℃ | ||||
| RT |
Cell Cycle Omics
CYCLoPs (Pol31-GFP)
| Gene / Allele | Actin Patch (Sac6-tdTomato) | Cortical Patch (Sla1-GFP) | Late Endosome (Snf7-GFP) | Vacuole (Sac6-tdTomato) |
|---|
| Gene | Images |
|---|
| Gene | Images |
|---|
Images are not yet available
Images are not yet available